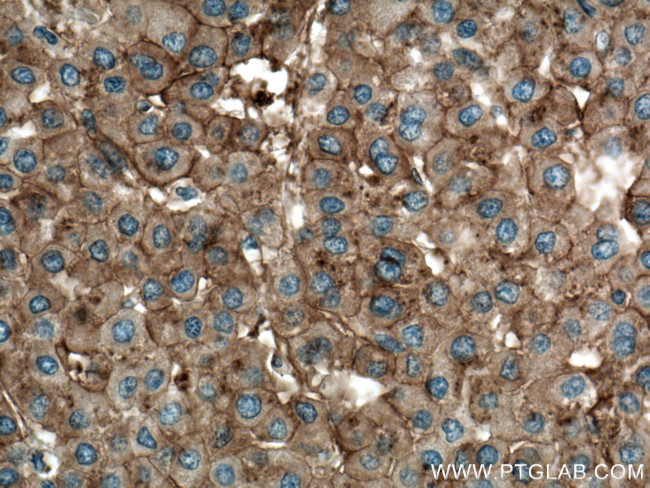
Apolipoprotein A II Antibody in Immunohistochemistry (Paraffin) (IHC (P))

Search
Proteintech
Apolipoprotein A II Monoclonal Antibody (1G1A2)
{{$productOrderCtrl.translations['antibody.pdp.commerceCard.promotion.promotions']}}
{{$productOrderCtrl.translations['antibody.pdp.commerceCard.promotion.viewpromo']}}
{{$productOrderCtrl.translations['antibody.pdp.commerceCard.promotion.promocode']}}: {{promo.promoCode}} {{promo.promoTitle}} {{promo.promoDescription}}. {{$productOrderCtrl.translations['antibody.pdp.commerceCard.promotion.learnmore']}}
产品信息
66773-1-IG
种属反应
宿主/亚型
分类
类型
克隆号
抗原
偶联物
形式
浓度
规格
纯化类型
保存液
内含物
保存条件
运输条件
产品详细信息
Immunogen sequence: MKLLAATVL LLTICSLEGA LVRRQAKEPC VESLVSQYFQ TVTDYGKDLM EKVKSPELQA EAKSYFEKSK EQLTPLIKKA GTELVNFLSY FVELGTQPAT Q (1-100 aa encoded by BC005282)
靶标信息
At least 9 distinct polymorphic forms of apolipoproteins are known. The apolipoproteins act as stabilizers of the intact lipoprotein particles. Quantitative measurements of HDL, LDL, and VLDL particles of human serum are often used to estimate an individual's relative risk of coronary heart disease. In addition, quantitative immunological measurements of certain apolipoproteins ( especially A-1 and B) have been suggested to be more accurate estimators of coronary heart disease that measurements of lipoprotein particles (especially HDL and LDL). The apolipoproteins are derived from human plasma by density gradient ultracentrifugation and HPLC.
仅用于科研。不用于诊断过程。未经明确授权不得转售。
篇参考文献 (0)
生物信息学
蛋白别名: APO A2; Apo-AII; Apolipoprotein; Apolipoprotein A-II; Apolipoprotein A2; Apolipoprotein AII; unnamed protein product
基因别名: Apo-AII; ApoA-II; APOA2; apoAII
UniProt ID: (Human) P02652
Entrez Gene ID: (Human) 336